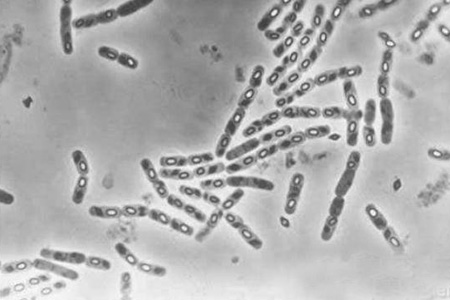
海洋生物生态调查

-
水色、透明度、嗅和味、水温、pH、悬浮物、盐度、浑浊度、溶解氧、化学耗氧量、生化需氧量、氨、铵盐、亚硝酸盐、硝酸盐、无机磷、总磷、总氮、…
-
化学需氧量、总磷、总氮、六价铬、pH、悬浮物、挥发酚、硫化物、汞、砷、硒、铜、铅、锌、镉、铬、镍、钴等。
-
含水率、硫化物、有机碳、氧化还原电位、铜、铅、镉、锌、铬、总汞、砷、油类、666、DDT、多氯联苯、粒度、苯系物等。
-
铜、铅、镉、锌、铬、总汞、砷、石油烃、666、DDT、多氯联苯、麻痹性贝类毒素、腹泻性贝类毒素等。
-
叶绿素-a、小型浮游生物调查、大、中型浮游生物调查、鱼类浮游生物调查、大型底栖生物调查、潮间带生物调查、粪大肠菌群、细菌总数、弧菌总数、…
-
海浪、海面有效能见度、天气现象、海面风、水深、海流等。
-
pH、水溶性盐总量、氯离子含量、硫酸根离子含量等。
联系我们
公司名称:大连海葵环境监测科技有限公司
公司地址:辽宁省大连高新技术产业园区广贤路107号1号楼3层
-
咨询热线
0411-84753885 -
销售热线
0411-84753885 -
公司传真
0411-84753885 -
邮政编码
116023 -
公司邮箱
dlhaikui@163.com